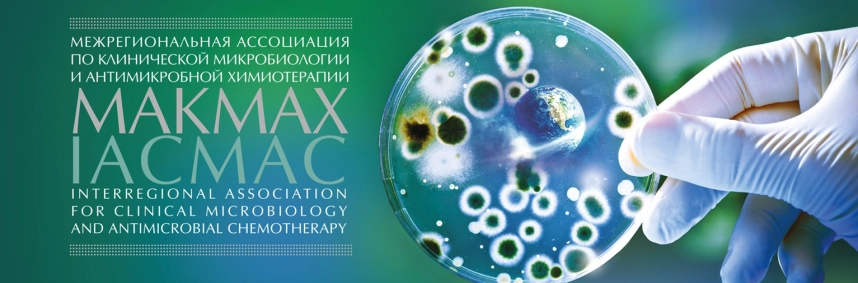

Данная организация находится в статусе «Архивная» — это означает, что с последнего её посещения под управляющим аккаунтом прошло более 365 дней.
Как такое могло произойти?
- был утерян доступ (логин/пароль) к управляющему аккаунту;
- был утерян доступ к привязанной почте;
- сотрудник вашей организации, который добавил организацию, более не работает в вашей организации.
В соответствии с правилами SciNetwork такие организации переводятся в статус «Архивная», а на её странице располагается данный информационный блок, чтобы дать возможность представителям организации восстановить доступ.
МАКМАХ ведёт совместную работу с Министерством здравоохранения Российской Федерации и международными обществами по клинической микробиологии и антимикробной резистентности.
МАКМАХ осуществляет мониторинг за резистентностью к антибиотикам на региональном и межрегиональном уровнях (программа RosNet).
МАКМАХ выпускает журнал и методическую литературу. Журнал «Клиническая микробиология и антимикробная химиотрапия» (КМАХ) распространяется бесплатно среди членов МАКМАХ и направляется в медицинские учреждения и библиотеки.
МАКМАХ проводит научные конференции, курсы последипломного образования и участвует в исследовательских проектах.
МАКМАХ — полноправный член FEMS
Издаваемые журналы
Сводная информация
- Полное название
-
МЕЖРЕГИОНАЛЬНАЯ АССОЦИАЦИЯ ОБЩЕСТВЕННЫХ ОБЪЕДИНЕНИЙ "МЕЖРЕГИОНАЛЬНАЯ АССОЦИАЦИЯ ПО КЛИНИЧЕСКОЙ МИКРОБИОЛОГИИ И АНТИМИКРОБНОЙ ХИМИОТЕРАПИИ"—
- Короткое название
-
МАКМАХ—
- Тип
- Научный центр